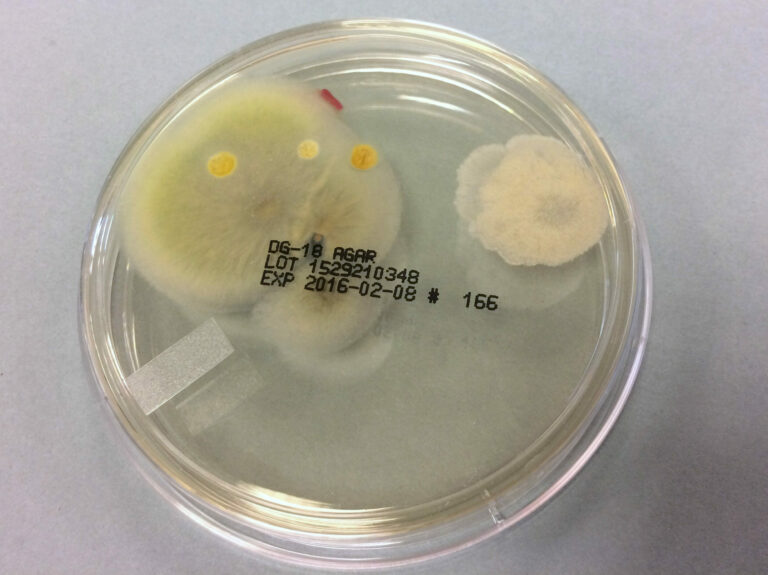
biologische toets_kweek1

Onderzoek & advies
Biologische toets

Bij overdracht van een archief naar een archiefbewaarplaats moet worden aangetoond dat het vrij is van ongedierte en schimmels. Wij voeren biologische toetsen uit om dit in kaart te brengen en leveren een rapport met daarin advies en eventueel te nemen maatregelen. De controle dient minimaal 14 dagen en maximaal twee maanden vóór de overdracht plaats te vinden.
Bij een (mogelijk) verontreinigd archief of depotruimte voeren wij uit:
- Controle op aanwezigheid van vuil, schimmelpluis, schimmelsporen en insecten zoals bijv. papiervisjes
- Bepalen of schimmel actief is door het nemen van strijk- en stempelmonsters
- Meting hygiënische kwaliteit van de lucht (hoeveelheid levende micro -organismen zoals bacteriën, schimmels en gisten per volume-eenheid)
- In kaart brengen van klimaatomstandigheden
- Monitoring van archieven en depotruimtes over een langere periode
Vraag hier een vrijblijvende offerte aan voor een biologisch onderzoek of mail naar cramer@atelierhoogduin.nl voor verdere informatie
Schade-inventariserend onderzoek



Wij hebben veel ervaring in het uitvoeren van schade-inventariserend onderzoek van een collectie of archief. Hiermee wordt inzicht gegeven in de conditie, de benodigde werkzaamheden om deze te verbeteren en de middelen die daarvoor nodig zijn. Ook een onderzoek naar de materiële samenstelling of verpakking van de collectie is mogelijk.
Denk aan:
- Het in kaart brengen van de raadpleegbaarheid
- Het bepalen van de meest urgente werkzaamheden vanuit materieel oogpunt, inclusief kostenindicatie
- Het onderzoeken van de frequentie van bepaalde verschijningsvormen, bijvoorbeeld t.b.v. digitalisering
- Het in kaart brengen van achterstanden m.b.t. de verpakking en de eisen van de Archiefwet
